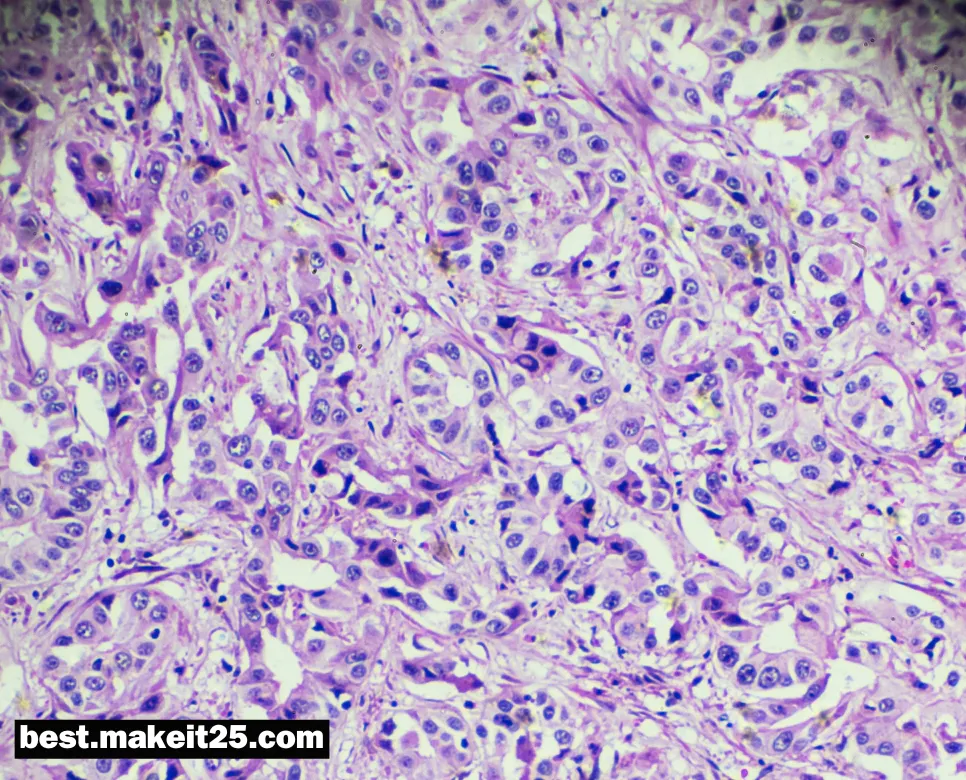

의학 용어 IM, HCC, RWMA는 각각 근육 내 주사, 간세포암, 국소 심벽 운동 이상을 의미합니다. 이 용어들은 약물 투여 경로, 간암의 가장 흔한 유형, 심장 초음파 검사에서 발견되는 이상 소견을 나타내는 중요한 개념입니다. IM은 백신 접종이나 특정 약물 투여에 사용되며, HCC는 만성 간질환 환자에서 주의 깊게 감시해야 할 질환이고, RWMA는 허혈성 심질환의 진단에 핵심적인 단서가 됩니다.
IM(근육 내)

IM은 의학 용어로 Intramuscular의 약자이며, 한글로는 ‘근육 내’를 의미합니다. 주사 경로 중 하나로, 약물이나 백신을 근육 조직 내에 직접 주입하는 방법입니다. 근육 내 주사는 피하 주사나 정맥 주사에 비해 약물의 흡수 속도가 비교적 느리고 지속 시간이 길어, 서방형 제제나 특정 백신 투여에 자주 사용됩니다.
근육 내 주사의 특징
- 주사 부위: 주로 삼각근, 둔부, 대퇴부 등 큰 근육 군에 주사합니다.
- 주사 바늘: 21~23게이지의 바늘을 사용하며, 주사 깊이는 근육의 크기에 따라 달라집니다.
- 약물 흡수: 근육 조직의 풍부한 혈류로 인해 약물이 비교적 빠르게 흡수되나, 피하 주사나 정맥 주사에 비해서는 느립니다.
- 통증: 근육 내 주사는 피하 주사에 비해 통증이 더 클 수 있습니다.
근육 내 주사의 적응증
- 백신 접종: 많은 백신이 근육 내 주사로 투여됩니다. (예: 인플루엔자 백신, B형 간염 백신 등)
- 항정신병 약물: 할로페리돌 데카노에이트, 리스페리돈 코나 등 장기 작용 항정신병 약물은 근육 내 주사로 투여됩니다.
- 진통제: 오피오이드 진통제 중 일부는 근육 내 주사로 투여할 수 있습니다.
- 응급 상황: 벤조디아제핀계 약물(디아제팜 등)은 경련 조절을 위해 근육 내 주사로 투여할 수 있습니다.
IM의 기타 의미
- Internal Medicine (내과): 내과 질환을 다루는 의학 분야를 지칭합니다.
- Intramedullary (골수내): 골수강 내부를 의미하며, 주로 정형외과 영역에서 사용됩니다. (예: 골수내 금속정 고정술)
- Immunology (면역학): 면역 체계와 관련된 생물학의 한 분야입니다.
요약하면, IM은 주로 근육 내 주사를 지칭하는 의학 약어로, 약물이나 백신을 근육 조직에 직접 주입하는 방법입니다. 백신 접종, 항정신병 약물 투여, 응급 상황에서의 약물 투여 등 다양한 적응증이 있습니다. 또한 IM은 내과, 골수내, 면역학 등의 의미로도 사용될 수 있습니다.
HCC(간세포암)
HCC는 의학 용어로 Hepatocellular Carcinoma의 약자이며, 한글로는 ‘간세포암’을 의미합니다. 간세포암은 간세포에서 기원하는 악성 종양으로, 전 세계적으로 가장 흔한 원발성 간암입니다. 만성 간질환, 특히 만성 B형 또는 C형 간염과 간경변증이 주요 위험 요인으로 알려져 있습니다.
간세포암의 위험 요인
- 만성 바이러스성 간염: 만성 B형 또는 C형 간염 바이러스 감염은 간세포암 발생의 가장 중요한 위험 요인입니다.
- 간경변증: 다양한 원인에 의한 만성 간질환의 말기 단계로, 간세포암 발생 위험을 현저히 증가시킵니다.
- 알코올 남용: 과도한 알코올 섭취는 간경변증을 유발하여 간세포암 발생 위험을 높입니다.
- 대사 증후군: 비만, 당뇨병, 고지혈증 등 대사 증후군의 구성 요소들은 간세포암 발생과 관련이 있습니다.
간세포암의 증상
- 복부 통증: 우상복부 불편감이나 통증이 나타날 수 있습니다.
- 체중 감소: 식욕 부진과 원인 불명의 체중 감소가 동반될 수 있습니다.
- 황달: 진행된 단계에서는 황달이 나타날 수 있습니다.
- 복수: 복강 내 액체 저류로 인해 복부 팽만이 관찰될 수 있습니다.
간세포암의 진단과 치료
- 영상 검사: 초음파, CT, MRI 등의 영상 검사를 통해 간 내 종괴를 발견할 수 있습니다.
- 조직 검사: 영상 검사로 진단이 불확실한 경우, 조직 검사를 시행하여 확진할 수 있습니다.
- 수술적 치료: 간 절제술 또는 간이식이 근치적 치료 방법입니다.
- 국소 치료: 고주파 열치료, 경동맥 화학색전술 등의 국소 치료를 시행할 수 있습니다.
- 전신 치료: 진행성 간세포암에서는 소라페닙, 레고라페닙 등의 표적 치료제나 면역 관문 억제제를 사용할 수 있습니다.
요약하면, HCC는 간세포에서 발생하는 악성 종양인 간세포암을 지칭하는 의학 약어입니다. 만성 바이러스성 간염과 간경변증이 주요 위험 요인이며, 복부 통증, 체중 감소, 황달 등의 증상이 나타날 수 있습니다. 영상 검사와 조직 검사를 통해 진단하며, 병기에 따라 수술, 국소 치료, 전신 치료 등을 선택적으로 시행합니다
RWMA(국소 심벽 운동 이상)

RWMA는 의학 용어로 Regional Wall Motion Abnormality의 약자이며, 한글로는 ‘국소 심벽 운동 이상’을 의미합니다. 심장 초음파 검사에서 심장 벽의 특정 부위가 정상적인 수축 및 이완 패턴에서 벗어나 있는 상태를 말합니다. RWMA는 주로 허혈성 심질환, 특히 심근경색의 진단에 중요한 단서가 됩니다.
RWMA의 평가
- 심장 초음파: 심장 초음파 검사는 RWMA를 평가하는 가장 기본적인 방법입니다. 2D 초음파, M-mode, 심장 도플러 등의 기법을 통해 심벽 운동을 실시간으로 관찰할 수 있습니다.
- 운동 부하 심장 초음파: 운동 또는 약물 부하 중 심장 초음파를 시행하여, 스트레스 상황에서의 RWMA 발생 여부를 확인할 수 있습니다.
- 심전도 동기화 영상 (ECG-gated imaging): 심전도와 동기화된 CT나 MRI 영상을 통해 심벽 운동을 평가할 수 있습니다.
RWMA의 원인
- 허혈성 심질환: 관상동맥 질환으로 인한 심근 허혈은 RWMA의 가장 흔한 원인입니다. 급성 심근경색 시 RWMA는 경색 부위와 일치하는 양상을 보입니다.
- 심근병증: 확장성 심근병증, 비후성 심근병증 등 다양한 심근병증에서 RWMA가 나타날 수 있습니다.
- 심장 전도 장애: 좌각차단 등 심장 전도 장애로 인해 비정상적인 심벽 운동이 나타날 수 있습니다.
- 심장 수술 후: 관상동맥 우회술 등 심장 수술 후 RWMA가 일시적으로 관찰될 수 있습니다.
RWMA의 임상적 의의
- 심근경색 진단: RWMA는 급성 심근경색의 진단에 중요한 역할을 합니다. 특히 심전도 변화가 명확하지 않은 경우, RWMA 평가가 진단에 결정적인 단서가 될 수 있습니다.
- 심근 생존력 평가: 만성 관상동맥 질환 환자에서 RWMA 부위의 생존력을 평가하여, 재개통술의 필요성과 예후를 예측할 수 있습니다.
- 심장 기능 평가: RWMA의 범위와 정도는 전체 심장 기능을 반영하므로, 심부전 환자의 평가와 치료 방침 결정에 도움이 됩니다.
요약하면, RWMA는 심장 초음파 검사에서 발견되는 국소 심벽 운동 이상을 의미하는 의학 약어입니다. 허혈성 심질환, 특히 급성 심근경색의 진단에 중요한 단서가 되며, 심근병증, 심장 전도 장애, 심장 수술 후에도 나타날 수 있습니다. RWMA의 평가는 심근경색의 진단, 심근 생존력 평가, 심장 기능 평가 등에 활용됩니다.
FAQ

Q: IM 주사 시 주의할 점은 무엇인가요?
A: IM 주사 시에는 무균 술기를 준수하고, 주사 부위를 적절히 선택하며, 신경이나 혈관 손상 위험을 최소화해야 합니다. 또한 주사 속도를 적절히 조절하고, 주사 후 부위를 압박하여 출혈과 반응을 예방해야 합니다.
Q: HCC의 조기 발견을 위해 어떤 검사를 시행하나요?
A: HCC의 고위험군(만성 B형 또는 C형 간염, 간경변증 환자 등)에서는 정기적인 감시 검사가 필요합니다. 일반적으로 6개월 간격의 복부 초음파와 혈청 알파태아단백(AFP) 검사를 시행하며, 필요 시 CT나 MRI를 추가로 시행합니다.
Q: RWMA가 있는 환자의 예후는 어떻게 되나요?
A: RWMA의 예후는 원인 질환, 범위, 심장 기능 등에 따라 다양합니다. 급성 심근경색에 의한 RWMA는 적절한 치료로 회복될 수 있으나, 광범위한 경색이나 심한 심부전이 동반된 경우 예후가 좋지 않습니다. 만성 허혈성 심질환에서의 RWMA는 재개통술 등의 치료로 개선될 수 있습니다.